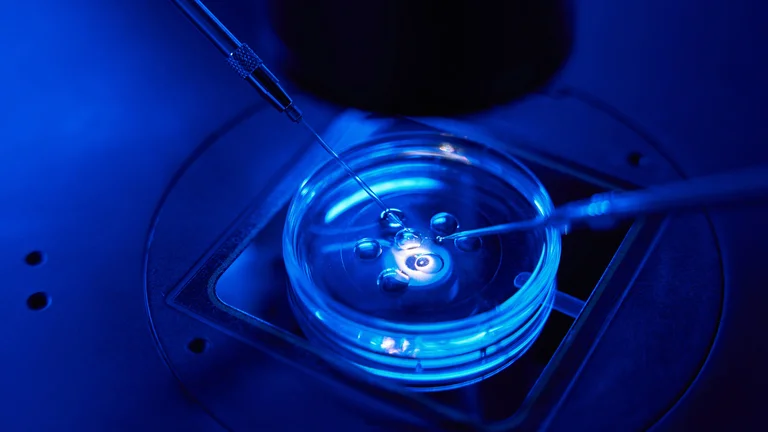

I. Name und Anschrift des Verantwortlichen
Der Verantwortliche im Sinne der Datenschutz-Grundverordnung und anderer nationaler Datenschutzgesetze der Mitgliedsstaaten sowie sonstiger datenschutzrechtlicher Bestimmungen ist die:
Bitte entnehmen Sie diese Angabe dem Impressum.
II. Kontakt Datenschutzbeauftragter
Der Datenschutzbeauftragte des Verantwortlichen ist wie folgt zu erreichen:
Bitte entnehmen Sie diese Angabe dem Impressum.
III. Allgemeines zur Datenverarbeitung
1. Umfang der Verarbeitung personenbezogener Daten
Wir erheben und verwenden personenbezogene Daten unserer Nutzer grundsätzlich nur, soweit dies zur Bereitstellung einer funktionsfähigen Website sowie unserer Inhalte und Leistungen erforderlich ist. Die Erhebung und Verwendung personenbezogener Daten unserer Nutzer erfolgt regelmäßig nur nach Einwilligung des Nutzers. Eine Ausnahme gilt in solchen Fällen, in denen eine vorherige Einholung einer Einwilligung aus tatsächlichen Gründen nicht möglich ist und die Verarbeitung der Daten durch gesetzliche Vorschriften gestattet ist.
Im Zeitpunkt der Absendung der Nachricht werden zudem folgende Daten gespeichert:
Es folgt eine Auflistung der entsprechenden Daten:
- Name der abgerufenen Datei
- Datum und Uhrzeit des Abrufs
- übertragene Datenmenge
- Meldung über erfolgreichen Abruf
- Webbrowser
- anfragende Domain
Zusätzlich werden die IP Adressen der anfragenden Rechner protokolliert.
Es verfolgt in diesem Zusammenhang eine Weitergabe der Daten an Dritte. Unsere Partnerfirma AmedickSommer (siehe Impressum) verarbeitet in unserem Auftrag diese Daten.
Auf unserer Internetseite sind Kontaktformulare vorhanden, welche für die elektronische Kontaktaufnahme oder Datenübermittlung genutzt werden können. Nimmt ein Nutzer diese Möglichkeit war, so werden die in der Eingabemaske eingegeben Daten an uns übermittelt und gespeichert. Diese Daten sind beispielsweise:
- Anrede
- Vorname
- Nachname
- E-Mail-Adresse
- Telefon
- Ihre Nachricht
Die Daten werden ausschließlich für die Verarbeitung der Konversation verwendet.
2. Rechtsgrundlage für die Verarbeitung personenbezogener Daten
Soweit wir für Verarbeitungsvorgänge personenbezogener Daten eine Einwilligung der betroffenen Person einholen, dient Art. 6 Abs. 1 lit. a EU-Datenschutzgrundverordnung (DSGVO) als Rechtsgrundlage für die Verarbeitung personenbezogener Daten.
Bei der Verarbeitung von personenbezogenen Daten, die zur Erfüllung eines Vertrages, dessen Vertragspartei die betroffene Person ist, erforderlich ist, dient Art. 6 Abs. 1 lit. b DSGVO als Rechtsgrundlage. Dies gilt auch für Verarbeitungsvorgänge, die zur Durchführung vorvertraglicher Maßnahmen erforderlich sind.
Soweit eine Verarbeitung personenbezogener Daten zur Erfüllung einer rechtlichen Verpflichtung erforderlich ist, der unser Unternehmen unterliegt, dient Art. 6 Abs. 1 lit. c DSGVO als Rechtsgrundlage.
Für den Fall, dass lebenswichtige Interessen der betroffenen Person oder einer anderen natürlichen Person eine Verarbeitung personenbezogener Daten erforderlich machen, dient Art. 6 Abs. 1 lit. d DSGVO als Rechtsgrundlage.
Ist die Verarbeitung zur Wahrung eines berechtigten Interesses unseres Unternehmens oder eines Dritten erforderlich und überwiegen die Interessen, Grundrechte und Grundfreiheiten des Betroffenen das erstgenannte Interesse nicht, so dient Art. 6 Abs. 1 lit. f DSGVO als Rechtsgrundlage für die Verarbeitung.
3. Datenlöschung und Speicherdauer
Die personenbezogenen Daten der betroffenen Person werden gelöscht oder gesperrt, sobald der Zweck der Speicherung entfällt. Eine Speicherung kann darüber hinaus dann erfolgen, wenn dies durch den europäischen oder nationalen Gesetzgeber in unionsrechtlichen Verordnungen, Gesetzen oder sonstigen Vorschriften, denen der Verantwortliche unterliegt, vorgesehen wurde. Eine Sperrung oder Löschung der Daten erfolgt auch dann, wenn eine durch die genannten Normen vorgeschriebene Speicherfrist abläuft, es sei denn, dass eine Erforderlichkeit zur weiteren Speicherung der Daten für einen Vertragsabschluss oder eine Vertragserfüllung besteht.
IV. Bereitstellung der Website und Erstellung von Logfiles
1. Beschreibung und Umfang der Datenverarbeitung
Bei jedem Aufruf unserer Internetseite erfasst unser System automatisiert Daten und Informationen vom Computersystem des aufrufenden Rechners.
Folgende Daten werden hierbei erhoben:
- Informationen über den Browsertyp und die verwendete Version
- Betriebssystem des Nutzers
- IP-Adresse des Nutzers
- Datum und Uhrzeit des Zugriffs
- Websites, von denen das System des Nutzers auf unsere Internetseite gelangt
- Name der abgerufenen Datei
- Dauer der Datenübertragung
- übertragene Datenmenge
Die Daten werden ebenfalls in den Logfiles unseres Systems gespeichert. Eine Speicherung dieser Daten zusammen mit anderen personenbezogenen Daten des Nutzers findet nicht statt.
2. Rechtsgrundlage für die Datenverarbeitung
Rechtsgrundlage für die vorübergehende Speicherung der Daten ist Art. 6 Abs. 1 lit. f DSGVO.
3. Zweck der Datenverarbeitung
Die vorübergehende Speicherung der IP-Adresse durch das System ist notwendig, um eine Auslieferung der Website an den Rechner des Nutzers zu ermöglichen. Hierfür muss die IP-Adresse des Nutzers für die Dauer der Sitzung gespeichert bleiben.
Die Speicherung in Logfiles erfolgt, um die Funktionsfähigkeit der Website sicherzustellen. Zudem dienen uns die Daten zur Optimierung der Website und zur Sicherstellung der Sicherheit unserer informationstechnischen Systeme. Eine Auswertung der Daten zu Marketingzwecken findet in diesem Zusammenhang nicht statt.
In diesen Zwecken liegt auch unser berechtigtes Interesse an der Datenverarbeitung nach Art. 6 Abs. 1 lit. f DSGVO.
Die Verarbeitung der personenbezogenen Daten aus der Eingabemaske dient uns allein zur Bearbeitung der Kontaktaufnahme. Im Falle einer Kontaktaufnahme per E-Mail liegt hieran auch das erforderliche berechtigte Interesse an der Verarbeitung der Daten.
Die sonstigen während des Absendevorgangs verarbeiteten personenbezogenen Daten dienen dazu, einen Missbrauch des Kontaktformulars zu verhindern und die Sicherheit unserer informationstechnischen Systeme sicherzustellen.
4. Dauer der Speicherung
Die Daten werden gelöscht, sobald sie für die Erreichung des Zweckes ihrer Erhebung nicht mehr erforderlich sind. Im Falle der Erfassung der Daten zur Bereitstellung der Website ist dies der Fall, wenn die jeweilige Sitzung beendet ist.
Für die personenbezogenen Daten aus der Eingabemaske des Kontaktformulars und diejenigen, die per E-Mail übersandt wurden, ist dies dann der Fall, wenn die jeweilige Konversation mit dem Nutzer beendet ist. Beendet ist die Konversation dann, wenn sich aus den Umständen entnehmen lässt, dass der betroffene Sachverhalt abschließend geklärt ist.
Im Falle der Speicherung der Daten in Logfiles ist dies nach spätestens neunzig Tagen der Fall. Eine darüberhinausgehende Speicherung ist möglich. In diesem Fall werden die IP-Adressen der Nutzer gelöscht oder verfremdet, sodass eine Zuordnung des aufrufenden Clients nicht mehr möglich ist.
Die während des Absendevorgangs zusätzlich erhobenen personenbezogenen Daten werden spätestens nach einer Frist von dreißig Tagen gelöscht.
5. Widerspruchs- und Beseitigungsmöglichkeit
Die Erfassung der Daten zur Bereitstellung der Website und die Speicherung der Daten in Logfiles ist für den Betrieb der Internetseite zwingend erforderlich. Es besteht folglich seitens des Nutzers keine Widerspruchsmöglichkeit.
Der Nutzer hat jederzeit die Möglichkeit, seine Einwilligung zur Verarbeitung der personenbezogenen Daten zu widerrufen. Nimmt der Nutzer per E-Mail Kontakt mit uns auf, so kann er der Speicherung seiner personenbezogenen Daten jederzeit widersprechen. Bitte entnehmen Sie die Kontaktdaten dem Impressum. In einem solchen Fall kann die Konversation nicht fortgeführt werden.
Alle personenbezogenen Daten, die im Zuge der Kontaktaufnahme gespeichert wurden, werden in diesem Fall gelöscht.
V. Verwendung von Cookies
a) Beschreibung und Umfang der Datenverarbeitung
Unsere Webeseite verwendet Cookies. Bei Cookies handelt es sich um Textdateien, die im Internetbrowser bzw. vom Internetbrowser auf dem Computersystem des Nutzers gespeichert werden. Ruft ein Nutzer eine Website auf, so kann ein Cookie auf dem Betriebssystem des Nutzers gespeichert werden. Dieser Cookie enthält eine charakteristische Zeichenfolge, die eine eindeutige Identifizierung des Browsers beim erneuten Aufrufen der Website ermöglicht. Die meisten der von uns verwendeten Cookies sind so genannte “Session-Cookies”. Sie werden nach Ende Ihres Besuchs automatisch gelöscht. Andere Cookies bleiben auf Ihrem Endgerät gespeichert bis Sie diese löschen. Diese Cookies ermöglichen es uns, Ihren Browser beim nächsten Besuch wiederzuerkennen.
Wir verwenden auf unserer Website darüber hinaus Cookies, die eine Analyse des Surfverhaltens der Nutzer ermöglichen. Die auf diese Weise erhobenen Daten der Nutzer werden durch technische Vorkehrungen pseudonymisiert. Daher ist eine Zuordnung der Daten zum aufrufenden Nutzer nicht mehr möglich. Die Daten werden nicht gemeinsam mit sonstigen personenbezogenen Daten der Nutzer gespeichert.
Beim Aufruf unserer Website werden die Nutzer durch einen Infobanner über die Verwendung von Cookies zu Analysezwecken informiert und auf diese Datenschutzerklärung verwiesen. Es erfolgt in diesem Zusammenhang auch ein Hinweis darauf, wie die Speicherung von Cookies in den Browsereinstellungen unterbunden werden kann.
b) Rechtsgrundlage für die Datenverarbeitung
Die Rechtsgrundlage für die Verarbeitung personenbezogener Daten unter Verwendung von Cookies ist Art. 6 Abs. 1 lit. f DSGVO.
c) Zweck der Datenverarbeitung
Der Zweck der Verwendung technisch notwendiger Cookies ist, die Nutzung von Websites für die Nutzer zu vereinfachen. Einige Funktionen unserer Internetseite können ohne den Einsatz von Cookies nicht angeboten werden. Für diese ist es erforderlich, dass der Browser auch nach einem Seitenwechsel wiedererkannt wird.
Die durch technisch notwendige Cookies erhobenen Nutzerdaten werden nicht zur Erstellung von Nutzerprofilen verwendet.
Die Verwendung der Analyse-Cookies erfolgt zu dem Zweck, die Qualität unserer Website und ihre Inhalte zu verbessern. Durch die Analyse-Cookies erfahren wir, wie die Website genutzt wird und können so unser Angebot stetig optimieren.
In diesen Zwecken liegt auch unser berechtigtes Interesse in der Verarbeitung der personenbezogenen Daten nach Art. 6 Abs. 1 lit. f DSGVO.
d) Dauer der Speicherung, Widerspruchs- und Beseitigungsmöglichkeit
Cookies werden auf dem Rechner des Nutzers gespeichert und von diesem an unserer Seite übermittelt. Daher haben Sie als Nutzer auch die volle Kontrolle über die Verwendung von Cookies. Durch eine Änderung der Einstellungen in Ihrem Internetbrowser können Sie die Übertragung von Cookies deaktivieren oder einschränken. Bereits gespeicherte Cookies können jederzeit gelöscht werden. Dies kann auch automatisiert erfolgen. Werden Cookies für unsere Website deaktiviert, können möglicherweise nicht mehr alle Funktionen der Website vollumfänglich genutzt werden.
VI. Rechte der betroffenen Person
Werden personenbezogene Daten von Ihnen verarbeitet, sind Sie Betroffener i.S.d. DSGVO und es stehen Ihnen folgende Rechte gegenüber dem Verantwortlichen zu:
1. Auskunftsrecht
Sie können von dem Verantwortlichen eine Bestätigung darüber verlangen, ob personenbezogene Daten, die Sie betreffen, von uns verarbeitet werden. Liegt eine solche Verarbeitung vor, können Sie von dem Verantwortlichen über folgende Informationen Auskunft verlangen:
(1) die Zwecke, zu denen die personenbezogenen Daten verarbeitet werden;
(2) die Kategorien von personenbezogenen Daten, welche verarbeitet werden;
(3) die Empfänger bzw. die Kategorien von Empfängern, gegenüber denen die Sie betreffenden personenbezogenen Daten offengelegt wurden oder noch offengelegt werden;
(4) die geplante Dauer der Speicherung der Sie betreffenden personenbezogenen Daten oder, falls konkrete Angaben hierzu nicht möglich sind, Kriterien für die Festlegung der Speicherdauer;
(5) alle verfügbaren Informationen über die Herkunft der Daten, wenn die personenbezogenen Daten nicht bei der betroffenen Person erhoben werden.
Ihnen steht das Recht zu, Auskunft darüber zu verlangen, ob die Sie betreffenden personenbezogenen Daten in ein Drittland oder an eine internationale Organisation übermittelt werden. In diesem Zusammenhang können Sie verlangen, über die geeigneten Garantien gem. Art. 46 DSGVO im Zusammenhang mit der Übermittlung unterrichtet zu werden.
2. Recht auf Berichtigung
Sie haben ein Recht auf Berichtigung und/oder Vervollständigung gegenüber dem Verantwortlichen, sofern die verarbeiteten personenbezogenen Daten, die Sie betreffen, unrichtig oder unvollständig sind. Der Verantwortliche hat die Berichtigung unverzüglich vorzunehmen.
3. Recht auf Einschränkung der Verarbeitung
Unter den folgenden Voraussetzungen können Sie die Einschränkung der Verarbeitung der Sie betreffenden personenbezogenen Daten verlangen:
(1) wenn Sie die Richtigkeit der Sie betreffenden personenbezogenen für eine Dauer bestreiten, die es dem Verantwortlichen ermöglicht, die Richtigkeit der personenbezogenen Daten zu überprüfen;
(2) die Verarbeitung unrechtmäßig ist und Sie die Löschung der personenbezogenen Daten ablehnen und stattdessen die Einschränkung der Nutzung der personenbezogenen Daten verlangen;
(3) der Verantwortliche die personenbezogenen Daten für die Zwecke der Verarbeitung nicht länger benötigt, Sie diese jedoch zur Geltendmachung, Ausübung oder Verteidigung von Rechtsansprüchen benötigen, oder
(4) wenn Sie Widerspruch gegen die Verarbeitung gemäß Art. 21 Abs. 1 DSGVO eingelegt haben und noch nicht feststeht, ob die berechtigten Gründe des Verantwortlichen gegenüber Ihren Gründen überwiegen.
Wurde die Verarbeitung der Sie betreffenden personenbezogenen Daten eingeschränkt, dürfen diese Daten – von ihrer Speicherung abgesehen – nur mit Ihrer Einwilligung oder zur Geltendmachung, Ausübung oder Verteidigung von Rechtsansprüchen oder zum Schutz der Rechte einer anderen natürlichen oder juristischen Person oder aus Gründen eines wichtigen öffentlichen Interesses der Union oder eines Mitgliedstaats verarbeitet werden.
Wurde die Einschränkung der Verarbeitung nach den o.g. Voraussetzungen eingeschränkt, werden Sie von dem Verantwortlichen unterrichtet bevor die Einschränkung aufgehoben wird.
4. Recht auf Löschung
a) Löschungspflicht
Sie können von dem Verantwortlichen verlangen, dass die Sie betreffenden personenbezogenen Daten unverzüglich gelöscht werden, und der Verantwortliche ist verpflichtet, diese Daten unverzüglich zu löschen, sofern einer der folgenden Gründe zutrifft:
(1) Die Sie betreffenden personenbezogenen Daten sind für die Zwecke, für die sie erhoben oder auf sonstige Weise verarbeitet wurden, nicht mehr notwendig.
(2) Sie widerrufen Ihre Einwilligung, auf die sich die Verarbeitung gem. Art. 6 Abs. 1 lit. a oder Art. 9 Abs. 2 lit. a DSGVO stützte, und es fehlt an einer anderweitigen Rechtsgrundlage für die Verarbeitung.
(3) Sie legen gem. Art. 21 Abs. 1 DSGVO Widerspruch gegen die Verarbeitung ein und es liegen keine vorrangigen berechtigten Gründe für die Verarbeitung vor, oder Sie legen gem. Art. 21 Abs. 2 DSGVO Widerspruch gegen die Verarbeitung ein.
(4) Die Sie betreffenden personenbezogenen Daten wurden unrechtmäßig verarbeitet.
(5) Die Löschung der Sie betreffenden personenbezogenen Daten ist zur Erfüllung einer rechtlichen Verpflichtung nach dem Unionsrecht oder dem Recht der Mitgliedstaaten erforderlich, dem der Verantwortliche unterliegt.
(6) Die Sie betreffenden personenbezogenen Daten wurden in Bezug auf angebotene Dienste der Informationsgesellschaft gemäß Art. 8 Abs. 1 DSGVO erhoben.
b) Information an Dritte
Hat der Verantwortliche die Sie betreffenden personenbezogenen Daten öffentlich gemacht und ist er gem. Art. 17 Abs. 1 DSGVO zu deren Löschung verpflichtet, so trifft er unter Berücksichtigung der verfügbaren Technologie und der Implementierungskosten angemessene Maßnahmen, auch technischer Art, um für die Datenverarbeitung Verantwortliche, die die personenbezogenen Daten verarbeiten, darüber zu informieren, dass Sie als betroffene Person von ihnen die Löschung aller Links zu diesen personenbezogenen Daten oder von Kopien oder Replikationen dieser personenbezogenen Daten verlangt haben.
c) Ausnahmen
Das Recht auf Löschung besteht nicht, soweit die Verarbeitung erforderlich ist
(1) zur Ausübung des Rechts auf freie Meinungsäußerung und Information;
(2) zur Erfüllung einer rechtlichen Verpflichtung, die die Verarbeitung nach dem Recht der Union oder der Mitgliedstaaten, dem der Verantwortliche unterliegt, erfordert, oder zur Wahrnehmung einer Aufgabe, die im öffentlichen Interesse liegt oder in Ausübung öffentlicher Gewalt erfolgt, die dem Verantwortlichen übertragen wurde;
(3) aus Gründen des öffentlichen Interesses im Bereich der öffentlichen Gesundheit gemäß Art. 9 Abs. 2 lit. h und i sowie Art. 9 Abs. 3 DSGVO;
(4) für im öffentlichen Interesse liegende Archivzwecke, wissenschaftliche oder historische Forschungszwecke oder für statistische Zwecke gem. Art. 89 Abs. 1 DSGVO, soweit das unter Abschnitt a) genannte Recht voraussichtlich die Verwirklichung der Ziele dieser Verarbeitung unmöglich macht oder ernsthaft beeinträchtigt, oder
(5) zur Geltendmachung, Ausübung oder Verteidigung von Rechtsansprüchen.
5. Recht auf Unterrichtung
Haben Sie das Recht auf Berichtigung, Löschung oder Einschränkung der Verarbeitung gegenüber dem Verantwortlichen geltend gemacht, ist dieser verpflichtet, allen Empfängern, denen die Sie betreffenden personenbezogenen Daten offengelegt wurden, diese Berichtigung oder Löschung der Daten oder Einschränkung der Verarbeitung mitzuteilen, es sei denn, dies erweist sich als unmöglich oder ist mit einem unverhältnismäßigen Aufwand verbunden.
Ihnen steht gegenüber dem Verantwortlichen das Recht zu, über diese Empfänger unterrichtet zu werden.
6. Recht auf Datenübertragbarkeit
Sie haben das Recht, die Sie betreffenden personenbezogenen Daten, die Sie dem Verantwortlichen bereitgestellt haben, in einem strukturierten, gängigen und maschinenlesbaren Format zu erhalten. Außerdem haben Sie das Recht diese Daten einem anderen Verantwortlichen ohne Behinderung durch den Verantwortlichen, dem die personenbezogenen Daten bereitgestellt wurden, zu übermitteln, sofern
(1) die Verarbeitung auf einer Einwilligung gem. Art. 6 Abs. 1 lit. a DSGVO oder Art. 9 Abs. 2 lit. a DSGVO oder auf einem Vertrag gem. Art. 6 Abs. 1 lit. b DSGVO beruht und
(2) die Verarbeitung mithilfe automatisierter Verfahren erfolgt.
In Ausübung dieses Rechts haben Sie ferner das Recht, zu erwirken, dass die Sie betreffenden personenbezogenen Daten direkt von einem Verantwortlichen einem anderen Verantwortlichen übermittelt werden, soweit dies technisch machbar ist. Freiheiten und Rechte anderer Personen dürfen hierdurch nicht beeinträchtigt werden.
Das Recht auf Datenübertragbarkeit gilt nicht für eine Verarbeitung personenbezogener Daten, die für die Wahrnehmung einer Aufgabe erforderlich ist, die im öffentlichen Interesse liegt oder in Ausübung öffentlicher Gewalt erfolgt, die dem Verantwortlichen übertragen wurde.
7. Widerspruchsrecht
Sie haben das Recht, aus Gründen, die sich aus ihrer besonderen Situation ergeben, jederzeit gegen die Verarbeitung der Sie betreffenden personenbezogenen Daten, die aufgrund von Art. 6 Abs. 1 lit. e oder f DSGVO erfolgt, Widerspruch einzulegen; dies gilt auch für ein auf diese Bestimmungen gestütztes Profiling.
Der Verantwortliche verarbeitet die Sie betreffenden personenbezogenen Daten nicht mehr, es sei denn, er kann zwingende schutzwürdige Gründe für die Verarbeitung nachweisen, die Ihre Interessen, Rechte und Freiheiten überwiegen, oder die Verarbeitung dient der Geltendmachung, Ausübung oder Verteidigung von Rechtsansprüchen.
Werden die Sie betreffenden personenbezogenen Daten verarbeitet, um Direktwerbung zu betreiben, haben Sie das Recht, jederzeit Widerspruch gegen die Verarbeitung der Sie betreffenden personenbezogenen Daten zum Zwecke derartiger Werbung einzulegen; dies gilt auch für das Profiling, soweit es mit solcher Direktwerbung in Verbindung steht.
Widersprechen Sie der Verarbeitung für Zwecke der Direktwerbung, so werden die Sie betreffenden personenbezogenen Daten nicht mehr für diese Zwecke verarbeitet.
Sie haben die Möglichkeit, im Zusammenhang mit der Nutzung von Diensten der Informationsgesellschaft – ungeachtet der Richtlinie 2002/58/EG – Ihr Widerspruchsrecht mittels automatisierter Verfahren auszuüben, bei denen technische Spezifikationen Recht auf Widerruf der datenschutzrechtlichen Einwilligungserklärung
Sie haben das Recht, Ihre datenschutzrechtliche Einwilligungserklärung jederzeit zu widerrufen. Durch den Widerruf der Einwilligung wird die Rechtmäßigkeit der aufgrund der Einwilligung bis zum Widerruf erfolgten Verarbeitung nicht berührt.
8. Recht auf Beschwerde bei einer Aufsichtsbehörde
Unbeschadet eines anderweitigen verwaltungsrechtlichen oder gerichtlichen Rechtsbehelfs steht Ihnen das Recht auf Beschwerde bei einer Aufsichtsbehörde, insbesondere in dem Mitgliedstaat ihres Aufenthaltsorts, ihres Arbeitsplatzes oder des Orts des mutmaßlichen Verstoßes, zu, wenn Sie der Ansicht sind, dass die Verarbeitung der Sie betreffenden personenbezogenen Daten gegen die DSGVO verstößt.
Die Aufsichtsbehörde, bei der die Beschwerde eingereicht wurde, unterrichtet den Beschwerdeführer über den Stand und die Ergebnisse der Beschwerde einschließlich der Möglichkeit eines gerichtlichen Rechtsbehelfs nach Art. 78 DSGVO.
VII. Analyse Tools
1. Matomo (ehemals Piwik)
Diese Website benutzt den Open Source Webanalysedienst Matomo. Matomo verwendet so genannte "Cookies". Das sind Textdateien, die auf Ihrem Computer gespeichert werden und die eine Analyse der Benutzung der Website durch Sie ermöglichen. Dazu werden die durch den Cookie erzeugten Informationen über die Benutzung dieser Website auf unserem Server gespeichert. Die IP-Adresse wird vor der Speicherung anonymisiert.
Matomo-Cookies verbleiben auf Ihrem Endgerät, bis Sie sie löschen.
Die Speicherung von Matomo-Cookies erfolgt auf Grundlage von Art. 6 Abs. 1 lit. f DSGVO. Der Websitebetreiber hat ein berechtigtes Interesse an der anonymisierten Analyse des Nutzerverhaltens, um sowohl sein Webangebot als auch seine Werbung zu optimieren.
Die durch den Cookie erzeugten Informationen über die Benutzung dieser Website werden nicht an Dritte weitergegeben. Sie können die Speicherung der Cookies durch eine entsprechende Einstellung Ihrer Browser-Software verhindern; wir weisen Sie jedoch darauf hin, dass Sie in diesem Fall gegebenenfalls nicht sämtliche Funktionen dieser Website vollumfänglich werden nutzen können.
Wenn Sie mit der Speicherung und Nutzung Ihrer Daten nicht einverstanden sind, können Sie die Speicherung und Nutzung hier deaktivieren. In diesem Fall wird in Ihrem Browser ein Opt-Out-Cookie hinterlegt, der verhindert, dass Matomo Nutzungsdaten speichert. Wenn Sie Ihre Cookies löschen, hat dies zur Folge, dass auch das Matomo Opt-Out-Cookie gelöscht wird. Das Opt-Out muss bei einem erneuten Besuch unserer Seite wieder aktiviert werden.
VIII. Newsletter
1. Newsletterdaten
Wenn Sie den auf der Website angebotenen Newsletter (z.B. Job-Agent) beziehen möchten, benötigen wir von Ihnen eine E-Mail-Adresse sowie Informationen, welche uns die Überprüfung gestatten, dass Sie der Inhaber der angegebenen E-Mail-Adresse sind und mit dem Empfang des Newsletters einverstanden sind. Weitere Daten werden nicht bzw. nur auf freiwilliger Basis erhoben. Diese Daten verwenden wir ausschließlich für den Versand der angeforderten Informationen und geben diese nicht an Dritte weiter.
Die Verarbeitung der in das Newsletteranmeldeformular eingegebenen Daten erfolgt ausschließlich auf Grundlage Ihrer Einwilligung (Art. 6 Abs. 1 lit. a DSGVO). Die erteilte Einwilligung zur Speicherung der Daten, der E-Mail-Adresse sowie deren Nutzung zum Versand des Newsletters können Sie jederzeit widerrufen, etwa über den "Austragen"-Link im Newsletter. Die Rechtmäßigkeit der bereits erfolgten Datenverarbeitungsvorgänge bleibt vom Widerruf unberührt.
Die von Ihnen zum Zwecke des Newsletter-Bezugs bei uns hinterlegten Daten werden von uns bis zu Ihrer Austragung aus dem Newsletter gespeichert und nach der Abbestellung des Newsletters gelöscht. Daten, die zu anderen Zwecken bei uns gespeichert wurden bleiben hiervon unberührt.
IX. Plugins und Tools
1. YouTube
Unsere Website nutzt Plugins der von Google betriebenen Seite YouTube. Betreiber der Seiten ist die YouTube, LLC, 901 Cherry Ave., San Bruno, CA 94066, USA.
Wenn Sie eine unserer mit einem YouTube-Plugin ausgestatteten Seiten besuchen, wird eine Verbindung zu den Servern von YouTube hergestellt. Dabei wird dem YouTube-Server mitgeteilt, welche unserer Seiten Sie besucht haben.
Wenn Sie in Ihrem YouTube-Account eingeloggt sind, ermöglichen Sie YouTube, Ihr Surfverhalten direkt Ihrem persönlichen Profil zuzuordnen. Dies können Sie verhindern, indem Sie sich aus Ihrem YouTube-Account ausloggen.
Die Nutzung von YouTube erfolgt im Interesse einer ansprechenden Darstellung unserer Online-Angebote. Dies stellt ein berechtigtes Interesse im Sinne von Art. 6 Abs. 1 lit. f DSGVO dar.
Weitere Informationen zum Umgang mit Nutzerdaten finden Sie in der Datenschutzerklärung von YouTube unter: https://www.google.de/intl/de/policies/privacy.
2. Google Maps
Diese Seite nutzt über eine API den Kartendienst Google Maps. Anbieter ist die Google Inc., 1600 Amphitheatre Parkway, Mountain View, CA 94043, USA. Die Datenverarbeitung für den europäischen Wirtschaftsraum und für die Schweiz wird durchgeführt von Google Ireland Limited, Gordon House, Barrow Street, Dublin 4, Irland
Zur Nutzung der Funktionen von Google Maps ist es notwendig, Ihre IP Adresse zu speichern. Diese Informationen werden in der Regel an einen Server von Google in den USA übertragen und dort gespeichert. Der Anbieter dieser Seite hat keinen Einfluss auf diese Datenübertragung.
Die Nutzung von Google Maps erfolgt im Interesse einer ansprechenden Darstellung unserer Online-Angebote und an einer leichten Auffindbarkeit der von uns auf der Website angegebenen Orte. Dies stellt ein berechtigtes Interesse im Sinne von Art. 6 Abs. 1 lit. f DSGVO dar.
Mehr Informationen zum Umgang mit Nutzerdaten finden Sie in der Datenschutzerklärung.
X. Schutz der Datenübertragung
1. SSL- bzw. TLS-Verschlüsselung
Diese Seite nutzt aus Sicherheitsgründen und zum Schutz der Übertragung vertraulicher Inhalte, wie zum Beispiel Bestellungen oder Anfragen, die Sie an uns als Seitenbetreiber senden, eine SSL-bzw. TLS-Verschlüsselung. Eine verschlüsselte Verbindung erkennen Sie daran, dass die Adresszeile des Browsers von “http://” auf “https://” wechselt und an dem Schloss-Symbol in Ihrer Browserzeile.
Wenn die SSL- bzw. TLS-Verschlüsselung aktiviert ist, können die Daten, die Sie an uns übermitteln, nicht von Dritten mitgelesen werden.